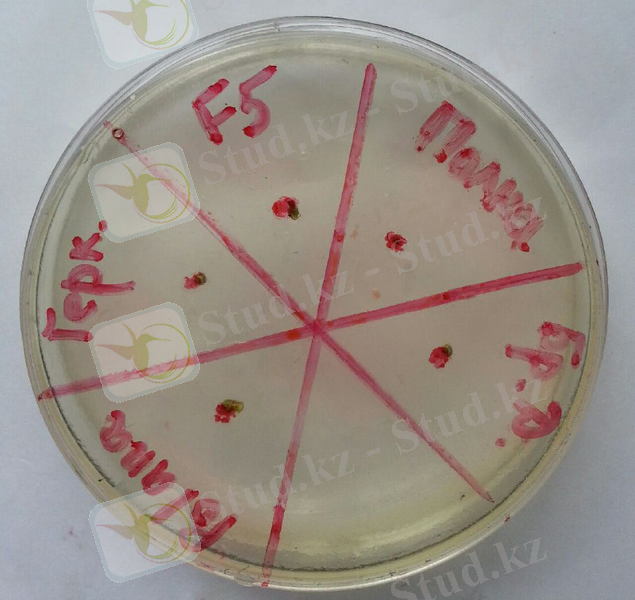
C:\Users\User\Documents\06ff692d-e3b9-4a97-a756-47853b8ff7dd.jpg

Геркулес, Брянская Диво, Полка, Полана және Форма 5 таңқурайларын in vitro микроклондық көбейту және апикалды меристемаларды криоконсервациялау әдістерін оңтайландыру


2. ЗЕРТТЕУ МАТЕРИАЛДАРЫ МЕН ӘДІСТЕРІ
2. 1 Зерттеу нысандары
Зерттеу нысандары таңқурайдың “Геркулес”, “Брянская Диво”, “Полка”, “Polana”сорттары мен“Форма 5” үлгісі.
2. 2 Зерттеу әдістері
Таңқурайдың сорттары мен гибридтік үлгісі үшін in vitro микроклондық көбейту әдісі, криоконсервация әдісі.
2. 2. 1 Таңқурайдың экспланттарын in vitro енгізу үрдісі
Таңқурайдың зерттеліп отырған сорттары мен гибридтік үлгісін in vitro жағдайға енгізу мен микроклондық көбейту үшін зертханалық жағдайда олардың бүршіктерін қоректік ортаға енгізілді.
Белсенді түрде өсіп жатқан, меристемалық аймаққа ие өркендер сабынды ерітінді негізінде жуылады да, кейіннен дистилденген сумен шайылды. Осыдан соң түрлі концентрация мен уақыт экспозициясы бойынша ажыратылатын залалсыздандырушы ерітінділермен өңделді.
Таңқурай сорттары мен гибридтік үлгісін асертикалық таза культураға отырғызу үшін сапрофитті микрофлорадан арылу мақсатында олардың өркендерін «Domestos» залалсыздандырғышымен (1:1) 7 минут және 10 минут, 3% сутегі асқын тотығымен (Н 2 О 2 ) 10 минут, сонымен бірге 0, 1% сулема (HgCl 2 ) ерітіндісімен 3 минут, 5 минут және 7 минут өңделді. Кейіннен таңқурай өркендері дистилденген стерильді сумен 3 рет шайылды да, арнайы пробиркалардағы қоректің ортаға енгізілді.
Таңқурайдың зерттеліп отырған сорттары мен гибридтік үлгісін in vitro енгізу мақсатында рН=5, 7тең МС ортасының 3 нұсқасы зерттелінді. Сәйкесінше олардың құрамындағы заттардың мөлшері әр түрлі:
1. БАП - 0, 02 мг/л, индолил-3-май-қышқылы (ИМҚ) - 0, 1 мг/л, гиббереллин қышқылы (ГҚ) - 0, 2 мг/л, АҚ- 1 мг/л, сахароза - 30 г/л, темір хелаты - 5 мг/л;
2. БАП - 0, 5 мг/л, индолил-3-май-қышқылы (ИМҚ) - 0, 2 мг/л, гиббереллин қышқылы (ГҚ) - 0, 5 мг/л, АҚ - 1 мг/л, глюкоза - 20 г/л, темір хелаты - 5 мг/л;
3. БАП - 0, 5 мг/л, индолил-3-май-қышқылы (ИМҚ) - 0, 1 мг/л, гиббереллин қышқылы (ГҚ) - 0, 2 мг/л, тиамин (В 1 витамині) - 0, 1 мг/л, АҚ - 1 мг/л, сахароза - 30 г/л, темір хелаты - 10 мг/л.
Кейіннен 3-4 апта өткен соң 1-1, 5 см ұзындығы сәйкес кесіліп алынған таңқурай өркендері МС қоректік ортасы болатын арнайы культуралдық банкілерге отырғызылды да, клонды микрокөбейтілді.
Көбіне өсімдіктерді клонды микрокөбейту барысында залалсыздандырылған өркендерде сапрофитті микрофлорадан басқа патогенді латентті микрофлора болуы мүмкін. Сондықтан мұндай қауіптін алдын-алу үшін оларды клонды көбейтпестен алдын рН=6, 9 болатын арнайы Viss қоректік ортасында тексеріп анықтаған дұрыс. Құрамындағы компоненттерінің барлығы түгел, дайын қоректік ортаны алдымен колбаның жартысындай мөлшерде құйып, фольгамен орап, 0, 8 атм. Қысымда 15-20 минуттай автоклавтайды. Кейіннен қоректік ортаныалдын ала залалсыздандырылған ламинарлы бокс астында пластикті Петри табақшаларына құйылып қойылады. Таңқурай өсімдіктерінің ұзындығы 5, 0 мм тең базальді бөлігі кесілген соң, құрамында MgSO 4 *7H 2 O− 0, 15 г/л, сахароза − 10, 0 г/л, казеин гидролизаты − 8, 0 г/л, ашытқы экстракті − 4, 0 г/л, джелрайт− 6, 0 г/, KH 2 PO 4 − 2, 0 г/л, болатын Viss ортасына отырғызылады да 25 С температурада 2 аптада төңірегінде культивирленеді. Қоректік ортада латентті микрофлора байқалмағанда орта көзге бірден мөлдірлігімен түседі, ал егер аталған көрініс байқалмаса ортада патогенді микрофлораның бар екендігі сөзсіз және мұндай өсімдіктер бірден асептикалық өсімдіктер қатарынан шығарылады. Ал қоректік ортасы таза өсімдіктермен микроклондық көбейту жұмыстары жалғасады.
2. 2. 2 Таңқурайдың сорттары мен гибридтік үлгісін in vitro микро клондық көбейту
Қазіргі таңда өсімдіктерді in vitro клонды микрокөбейту әдісі жемісті культуралардың сау егін материалын жылдам уақыт аралығында өндіру жүйесінде кеңінен қолданылу мүмкіншілігіне ие болды. Сәйкесінше аталмыш әдісте әр өсімдіктің түрі мен тұқымдасына сай арнайы қоректік орталар пайдаланылады.
In vitro клонды микрокөбейту әдісі көмегімен өсімдіктердің санын арттырып, көбейтуде көбіне Мурасиге және Скуг қоректік ортасы пайдаланылады. Сондай-ақ in vitro экспланттарды культивирлеуге қажетті оңтайлы ортаның қалыптасуы үшін зерттеу жұмыстары негізінде таңдалынып алынған қоректік ортаның құрамындағы цитокиндер мен ауксиндер мөлшерінің қатынасы өте маңызды. Зерттелген цитокиндердің (зеатин, кинетин және БАП) ішінде өсімдіктің клонды микрокөбею деңгейін 7, 2 дейін арттыратын БАП өз тиімділігін көрсететіндігі белгілі. Көбіне қоректік орта құрамындағы в-индолил май қышқылын 0, 05-0, 10 мг/л төңірегінде 0, 5 мг/л 6-БАП-пен бірге пайдалану таңқурай өсімдігінің микроөркендерінің регенерациялану қабілетіне оң әсерін береді. Е. В. Колбанованың айтуынша аталған сатыда МС қоректік ортасына 3 г/л сахароза мен 0, 5 мг/л 6-БАП-ты қолдану өсімдіктердің микрокөбею деңгейін арттырады.
Сонымен қоса қоректік ортаның зерттеліп отырған өсімдік үшін оңтайлылығының дәлелі аталмыш өсімдіктің сол ортадағы көбею коэффицентінің мәні болып саналады.
Басқаша айтсақ, көбею коэффиценті дегеніміз пайда болған адвентивті өркендеріміздің толық сандық көрсеткішін қоректік ортаға енгізілген микроөркендердің сандық көрсеткішіне қатынасымен анықталынады.
In vitro таңқурай сорттары мен гибридтік үлгісін микроклондық көбейту мақсатында МС қоректік ортасының құрамындағы реттегіштер, макротұздар және темір хелатын оңтайландыру үшін олардың түрлі концентрацияларының қатынасында қоректік орталар жасалынды. Агары бар МС қоректік ортасының 5 нұсқасына зерттеу жұмыстары өткізілді:
1. ИМҚ - 0, 1 мг/л, АҚ - 1 мг/л, БАП - 0, 1 мг/л, ГҚ - 0, 02 мг/л, В 1 витамині - 0, 5 мг/л, глюкоза - 30 г/л;
2. ИМҚ - 0, 1 мг/л, БАП - 0, 5 мг/л, В 1 витамині - 0, 1 мг/л, сахароза - 30 г/л;
3. ИМҚ - 0, 1 мг/л, АҚ - 2 мг/л, БАП - 0, 5 мг/л, ГҚ - 0, 1 мг/л, В 1 витамині - 10 мг/л, сахароза - 30 г/л;
4. ИМҚ - 0, 2 мг/л, АҚ - 1 мг/л, БАП - 0, 1 мг/л, ГҚ - 0, 01 мг/л, В 1 витамині - 0, 5 мг/, глюкоза - 30 г/л, ;
5. ИМҚ - 0, 1 мг/л, АҚ - 1 мг/л, БАП - 0, 3 мг/л, В 1 витамині - 0, 01 мг/л, сахароза - 30 г/л;
2. 2. 3 Өсімдіктерден апикальды меристемалар оқшаулау
Апикалды меристемаларды бөлу үшін 4 апта культивирленген өсімдіктер алынады. Олардың 3-4 жапырақ пен апикалды меристемадан құрылған 0, 9-1, 0 мм өркендерінің апекстерінен аталған апикалды меристема бөлініп алынды. Апикалды меристеманы қандай да бір зақымдалусыз бөлу күрделі жұмыс болғандықтан, оларды бірнеше жапырағымен бірге бөлінді.
Аталған процесс ламинарлы бокс астында бинокулярлы микроскоп көмегімен жүргізіледі. Апикалды меристемалар құрғап кетпеу мақсатында алдын-ала залалсыздандырылған және дистилденген су көмегімен ылғалды күйдегі қағаздың бетінде бөлінді. Кейіннен Мурасиге және Скуг ортасына отырғызылды.
2. 2. 4 Таңқурай өсімдіктерін тамырландыру мен жылыжай жағдайына көшіру сатысы
Тамырлану процесі. Тамырландыру -клонды микрокөбейту әдісіндегі күрделі саты болып саналады. Бұл сатыда қоректік ортаның құрамын біршама өзгерту қажет, яғни ортадағы цитокиндер мөлшері жоғарылап, ауксиндер мөлшері керісінше азаяды. Алайда ортадағы ауксиндер мөлшерінің оңтайлы болуы маңызды. Себебі ауксиндердің өсімдікке ұзақ уақыт әсер етуі мен мөлшерінің жоғары болуы олардың тез қартаю көрсеткіштеріне байланысты. Мысалы өркендердің тамырлануға бейімдеушілік деңгейі, қолданылатын ауксиннің түрі, сонымен бірге фитогормондардың өзара қатынасы.
Таңқурай өсімдіктеріндегі тамырландыру процесін жүзеге асыру үшін құрамындағы қосылыстары өзара мөлшері бойынша әр түрлі болатын МС қоректік ортасының 3 түрлі нұсқасына зерттеу жұмыстары өткізілді:
1. АҚ - 0, 5 мг/л, В 1 витамині - 0, 05 мг/л, сахароза - 15 г/л, ИМҚ - 0, 5 мг/л, ГҚ - 0, 3 мг/л;
2. ½ МС : АҚ - 0, 2 мг/л, сахароза - 15 г/л, ИМҚ - 0, 20 мг/л, ГҚ - 0, 1 мг/л, ;
3. АҚ - 0, 4 мг/л, В 1 витамині - 0, 01 мг/л, сахароза - 15 г/л, глицин - 2 мг/л ГҚ - 0, 1 мг/л.
Тамырлануға арналған МС ортасына отырғызылған өсімдіктер 22С-24 ° С температурада жарық бөлмеде өсіріледі.
Таңқурай сорттары мен гибридтік үлгісін топыраққа ауыстыру. In vitro жағдайында микрокөбейтілген таңқурай өсімдіктері тамырлануға арналған МС ортасында жақсы тамырланғандары таңдалынып алынып, содан соң 2-3 аптадан кейін in vіtro жағдайдан in vivo жағдайға ауысады. Өсімдіктерді топырақты контейнерге көшірмей тұрып калий перманганатының (K 4 MnO 4 ) әлсіз ерітіндісіне (1мг/л) батырады да, оларды залалсыздандырады.
Зерттеу жұмыстары үшін топырақты субстраттың 3 түрлі нұсқасы зерттелінді:
- 40% қара топырақ, 50% торф, 10% перлит;
- 80% қара топырақ, 20% торф;
- 50% қара топырақ пен 50% құм.
3. ЗЕРТТЕУ НӘТИЖEЛЕРІ ЖӘНЕ ОЛАРДЫ ТАЛҚЫЛАУ
3. 1 Таңқурайдың сорттары мен үлгісін in vitro жағдайына енгізу мен патогенді инфекцияға тексеру
Таңқурай өсімдігінің апикалды өркендерін залалсыздандыру жұмысы негізінде аталған таңқурай өсімдіктеріндегі сапрофитті инфекциялы микрофлораның дамуын тежеуде оңтайлы залалсыздандырғыш агент ретінде 5 минут бойы 0, 1% HgCl 2 ерітіндісімен өңдеу таңдалынып алынды. Сулема ерітіндісімен өсімдікті 3 минут өңдеу кезінде олардағы сапрофитті микрофлораның жоғалу дәрежесі төмен болса, ал оларды 7 минут өңдеу барысында өсімдіктердің регенерациялану деңгейі төмендеп, жапырақтардың бояулары өзінің қанық жасыл түсін жоғалта бастады.
Оңтайлы болып таңдалған сулема ерітіндісімен 5 минут өңдеу кезінде болса зерттелініп отырған таңқурай өсімдіктерінің жалпы регенерациялану көрсеткіші 95% немесе «Брянская Диво» сортында 95%, «Полка» сортында 96%, «Геркулес» сортында 93%, «Полана» сортында 94 %және «F 5» үлгісінде 97% құрады (сурет 2) . Ал басқа залалсыздандырғыштар өсімдіктің регенерациялық қабілетінің көрсеткішіне кері әсер етті. Мысалы, 3% сутегі асқын тотығымен (Н 2 О 2 ) 10 минут өңдеудің нәтижесінде өсімдіктердің регенерациялану көрсеткіші 36, 4% аспады.
Сурет 2 - Таңқурайдың зерттелген өсімдіктері өркендерінің кейінгі регенерациялануы
Өсімдіктерді in vitro енгізу кезінде қоректік ортаны құраушы заттар мен олардың мөлшері үлкен рөлге ие екендігі белгілі. Қоректік ортаның химиялық құрамы мен физикалық қасиеті клонды микрокөбейтудің әр сатысындағыдай өз рөлін дұрыс атқаруы тиіс. Қоректік орта құрамындағы антиоксиданттар гидролитикалық ферменттердің әсерін мен отырғызылған экспланттардың тіршілігінің тоқталуының алдын алады.
Белсенді көмірдің қоректік ортада болуы өркендердің өсуіне ықпал етеді. Ол экспланттан бөлінетін токсикалық заттарды адсорбциялайды. Сонымен бірге белсенді көмір ортадан биологиялық белсенді қосылыстарды адсорбциялау арқылы олардың мөлшерін азайтады. Сондықтан аталмыш қосылыс бар ортада фитогормондардың үлкен концентрациясы қажет. Біздер зерттеу жұмысының барысында таңқурай өсімдіктерін in vitro жағдайына енгізуде оңтайлы орта болып құрамында темір хелаты - 10 мг/л, БАП - 0, 5 мг/л, ИМҚ - 0, 1 мг/л, ГҚ - 0, 2 мг/л, глицин - 2 мг/л, В1 витамині - 0, 1 мг/л және сахароза - 30 г/л бар МС қоректік ортасында екендігі белгілі болды. Ортадағы темір хелатының өсімдіктерге негізгі әсері олардағы регенерациялану деңгейін көтеруде болды. Жалпы зерттелініп отырған өсімдіктер үшін регенерациялану көрсеткіші 95% (кесте 2, 3) . Сонымен қоса регенерацияға ортадағы ИМҚ да әсер етті, ол өсімдіктердердің өміршеңдігін ұзартуға жауапты екендігі белгілі.
Кесте 2 - Таңқурайдың «Полка», «Полана» мен «Геркулес» сорттарын in vitro енгізу негізінде қоректік ортаның әсер етуі
Қоректік орта нұсқалары мен фитогормондар
концентрациясы, мг/л
Кесте 3 - Таңқурайдың «Брянская Диво» сорты мен «Форма 5» үлгісін in vitro енгізу негізінде қоректік ортаның әсер етуі
Қоректік орта нұсқалары мен фитогормондар
концентрациясы, мг/л
Дегенмен, зерттеу жұмысының нәтижесінде ортада 0, 5 мг/л БАП пен 0, 2 мг/л ГҚ болуы таңқурай микроөркендерінің регенерациясы үшін тиімді болып танылды. Әдетте ортада цитокиндер болмаса микроөркендердің даму көрсеткіші төмен болады. Қоректік орта құрамындағы антиоксиданттардың болуы өсімдіктердегі морфогенез процесінің бүзылуының алдын алады. Себебі ортадағы фенолды қосылыстар тотыққанда аталмыш процесс орын алады, ал антиоксиданттар олардың ортадағы мөлшерін төмендетуге тырысады. Сәйкесінше қоректік ортада көзге бірден көрінетін қараю процесі жүрмейді.
Соның нәтижесінде таңқурайдың «Брянская Диво», «Полка», «Полана» сорттарында бактериялық микрофлораға ұшырау белгілері көрінсе, ал «Геркулес» сорты мен «F 5» үлгісінде патогенді микрофлора байқалмады (кесте 4) .
Кесте 4 - Таңқурай экспланттарын Viss ортасында тексеру
А - инфекцияның болмауы
Сурет 3 -Жасырын микрофлораңа оқшауланған таңқурай апекстерін
тексеру
3. 2 Таңқурайдың сорттары мен гибридтік үлгісін in vitro жағдайында микроклондық көбейту
Қазіргі уақытта өсімдіктердің алуантүрлілігін сақтау мен in vitro генетикалық банкті жасау мақсатында клонды микрокөбейту процесі өсімдіктерді жыл мезгіліне тәуелсіз көбейте алу мен асептикалық сау өсімдіктерді алу мүмкіншілігіне ие болғандықтан биотехнология саласында кеңінен пайдаланылуда. Әдетте клонды микрокөбейту үшін көптеген қоректік орталар, атап айтқанда Мурасиге және Скуг, Уайт, Lepoivre, Woody Plant Medium және т. б. қолданылады. Кей жаағдайда клонды микроккөбейту үшін өсімдіктерді in vitro енгізуге қолданған қоректік орртаны пайдаланады немесе морфогенетикалық реакцияны индуцирлейтін фитогормондармен ортаны байытып, екінші рет пайдаланады. Таңқурай сорттары мен үлгісін зерттеу үшін МС ортасы таңдалынып алынды. Аталған сатыда өсімдіктердің өсуі мен дамуына жауапты қоректік ортаның негізгі құрамдас бөлігі болып табылатын цитокиндер мен ауксиндердің әсері анықталды. Экзогенді фитогормондар көмегімен морфогенезді реттеу клонды микрокөбейтудің негізі болып саналады. Кеңінен қолданылатын цитокиндердің қатарына БАП, зеатин, кинетин жатса, ал ауксиндерге 0, 5 мг/л мөлшеріне дейінгі ИСҚ мен ИМҚ жатады.
Таңқурай өсімдіктерін культивирлеуде Ruzic D. жұмыстарында көрсетілгендей қоректік ортадағы БАП концентрациясы 0, 5 мг/л және ИМҚ 0, 1 мг/л болуы микроөркендердің дұрыс дамуына әсер етті. Кей зерттеушілердің зерттеуінде БАП мөлшері көбейген сайын өсімдіктің көбею коэффиценті жоғары болады деп көрсетіледі. Алайда Пронина БАП, кинетин және зеатиннің өсімдіктің көбею коэффицентіне әсерін анықтау үшін жасаған жүмыстарының нәтижесінде БАП мөлшерінің 1, 5-2, 0 мг/л шамасында болуы көбею көрсеткішін төмендетіп, өркендердің дамуын тоқтатып жіберді. Басқа зерттеуші айтуынша ортада БАП 1, 0 мг/л болса, өсімдік жылдам өсетіндігін сипаттаған. Алайда БАП мөлшері ортада үлкен болғанда онда ИСҚның аз мөлшерін ( БАП 2, 23 мг/л ИСҚ 0, 173 мг/л) қосу арқылы БАПтың өсімдікке деген кері әсерін төмендету мүмкіндігі қарастырылды. Поповтың зерттеулері бойынша микроөркендерді БАП мөлшері жоғары ортада ұзақ уақыт культивирлеу олардың пролиферация мен тамыр жүйесінің түзілуіне кері процесті тудыратын құбылысұа әкелетіндігін дәлелдеді. Оның айтуынша микроөркендкрді культивирлеу кезінде олардың тіндерінде физиологиялық деңгейден жоғары фитогормондардың жиналуы орын алады да, өсімдікке қатысты токсикалық әсер пайда болады. Цитокиндердің мұндай кері әсерін тұрақты көбею коэффицентін қамтамасыз ететін минималды мөлшерін ортаға қосу арқылы жеңуге болады. Клонды микрокөбейтудің барлық сатысында көміртегі көзі ретінде сахароза пайдаланылады. Өркендердің дамуында сахарозаны 3% мөлшерінде қолдану олардың тыныштық күйге кетуіне алып келеді немесе экспланттардың тіршілігін тоқтатады. Сондықтан ортадағы сахароза мөлшерін төмендету арқылы ары қарайғы көбею процесіне қатысатын жасыл өркендердің дамуын ынталандыруға болады. Сонымен қоса қоректік орта құрамындағы табиғаты гормон емес заттарда (витаминдер, амин қышқылы, казеин гидролизаты, өсімдіктектес экстрактілер) клонды микрокөбейту процесіне әсер етеді.
Біздер жасаған зерттеу жұмыстары бойынша таңқурай өсімдіктері БАП1, 0 мг/л мөлшерде, ал ГҚ 0, 5 мг/л болғанда көбею коэффицентінің артуы байқалмады. Әдетте ортағы БАП мөлшері 0, 5-1, 5 мл аралығында қосылуы қажетті нәтижені беруге көмектеседі.
Басқа зерттеулерде дамып жатқан микроөркендердің морфологиясына ИМҚ фитогормонының оң әсері де анықталған. Мысалы, қоректік ортада оның мөлшері 0, 5 мг/л болғанда микроөркендердің ұзындығы 2, 5 есе артқан.
Таңқурай сорттар мен гибридтік үлгісін in vitro клонды микрокөбейтуде зерттелген 5 түрлі МС ортасынан өсімдіктің өсуі мен дамуына оңтайлы орта болып құрамында БАП - 0, 5 мг/л, ИМҚ - 0, 1 мг/л, В 1 витамині - 0, 1 мг/л, мезоинозит - 100 мг/л, глицин - 2 мг/л, темір хелаты - 5 м/л, В6 мен РР витаминдері - 0, 5 мг/л, сахароза - 30 г/л болатын, рН= 5, 8 жеткізілген соң агар - 3, 5 г/л, джелрайт − 3, 5 г/л қосылған нұсқа таңдалынды. Зерттеліп отырған өсімдіктердің көбею коэффиценті 4, 32 болды немесе «Polana» сортында 4, 3, «Геркулес» сортында 4, 6, «Полка» сортында 4, 2 болса, ал «F 5» үлгісінде 4, 1 және «Брянская Диво» сортында 4, 4деген көрсеткішке ие болды (сурет 4) .
1. ИМҚ - 0, 1 мг/л, АҚ - 1 мг/л, БАП - 0, 1 мг/л, ГҚ - 0, 02 мг/л, В 1 витамині - 0, 5 мг/л, глюкоза - 30 г/л;
2. ИМҚ - 0, 1 мг/л, БАП - 0, 5 мг/л, В 1 витамині - 0, 1 мг/л, сахароза - 30 г/л;
3. ИМҚ - 0, 1 мг/л, АҚ - 2 мг/л, БАП - 0, 5 мг/л, ГҚ - 0, 1 мг/л, В 1 витамині - 10 мг/л, сахароза - 30 г/л;
4. ИМҚ - 0, 2 мг/л, АҚ - 1 мг/л, БАП - 0, 1 мг/л, ГҚ - 0, 01 мг/л, В 1 витамині - 0, 5 мг/, глюкоза - 30 г/л, ;
5. ИМҚ - 0, 1 мг/л, АҚ - 1 мг/л, БАП - 0, 3 мг/л, В 1 витамині - 0, 01 мг/л, сахароза - 30 г/л;
Сурет 4 - Микроклондық көбейтуге арналған қоректік орталар нұсқалары
Көбейген таңқурай өсімдіктерінің жапырақтарының хлорофилі жеткілікті, қанық қою жасыл түсті болса, ал сабақтар жуан, ұзын әрі беріктікпен ерекшеленді. Олар 3-4 апта сайын жаңа ортаға көшіріліп отырылды, орташа бір культуралық банкіге 12-15 өсімдік отырғызылды. Осының негізінде клонды микрокөбейту арқылы таңқурай өсімдігінің коллекциясы жасалынды (сурет 5) .





А - Геркулес Б - Полка В - Polana
Г - Брянская Диво Д - F 5
Сурет 5 - Таңқурай сорттары мен үлгісінің микроклондық көбейтілуі
Оқшауланған өсімдік тіндерін люминесцентті лампа жарығы қатысында, өсімдіктің фотопериодтық жағдайын ескеріп, өсіреді. Әдетте клонды микрокөбейтуде өсімдіктер 1000-5000лк және 14-16 фотопериод жағдайында культивирленеді, өйткені мұндай жағдай көптеген өсімдіктерде өркендер мен тамыр жүйесінің дамуына әсер етеді. Ал өсімдік өсетін бөлме температурасы олардағы метаболизмдік және регенерациялық процестерді бақылайды. Температура өсімдіктін түріне және сортына байланысты әр түрлі болып таңдалынады. Көптеген өсімдік тіндері үшін оптималды температура23-25С болып табылады (сурет 6)
.
3. 3 Таңқурай сорттары мен гибридтік үлгісінің апикальды меристемаларын криосақтау

Сурет 7 - In vitro ауыспалы температурада 2 апта акклиматизациялануда болған таңқурай өсімдіктері




Сурет 8 - Таңқурай өсімдіктерінен апикалды меристемаларды бөлу және криоконсервациялау үрдісі
PVS2-мен өңдеген соң таңқурай меристемаларының өміршеңдік көрсеткіштері біршама төмендеді (кесте 5) .
Кесте 5 - PVS2-ден соң бақылау
Кесте 6 - Жоғары температурамен өңдегеннен соң меристемалар
... жалғасы- Іс жүргізу
- Автоматтандыру, Техника
- Алғашқы әскери дайындық
- Астрономия
- Ауыл шаруашылығы
- Банк ісі
- Бизнесті бағалау
- Биология
- Бухгалтерлік іс
- Валеология
- Ветеринария
- География
- Геология, Геофизика, Геодезия
- Дін
- Ет, сүт, шарап өнімдері
- Жалпы тарих
- Жер кадастрі, Жылжымайтын мүлік
- Журналистика
- Информатика
- Кеден ісі
- Маркетинг
- Математика, Геометрия
- Медицина
- Мемлекеттік басқару
- Менеджмент
- Мұнай, Газ
- Мұрағат ісі
- Мәдениеттану
- ОБЖ (Основы безопасности жизнедеятельности)
- Педагогика
- Полиграфия
- Психология
- Салық
- Саясаттану
- Сақтандыру
- Сертификаттау, стандарттау
- Социология, Демография
- Спорт
- Статистика
- Тілтану, Филология
- Тарихи тұлғалар
- Тау-кен ісі
- Транспорт
- Туризм
- Физика
- Философия
- Халықаралық қатынастар
- Химия
- Экология, Қоршаған ортаны қорғау
- Экономика
- Экономикалық география
- Электротехника
- Қазақстан тарихы
- Қаржы
- Құрылыс
- Құқық, Криминалистика
- Әдебиет
- Өнер, музыка
- Өнеркәсіп, Өндіріс
Қазақ тілінде жазылған рефераттар, курстық жұмыстар, дипломдық жұмыстар бойынша біздің қор #1 болып табылады.



Ақпарат
Қосымша
Email: info@stud.kz